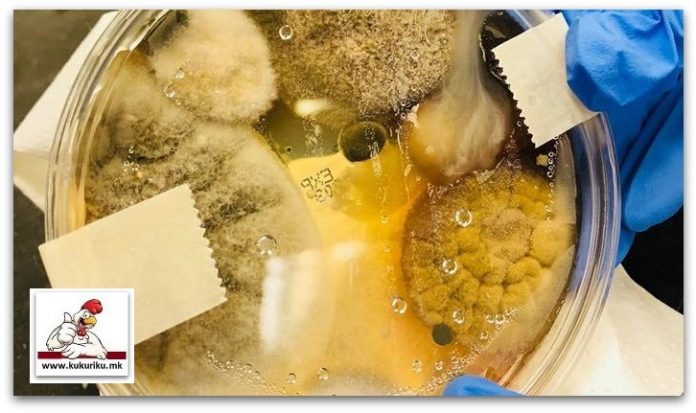

Nicole Ward три минути ја држела чинијата на Петри во апаратот за сушење на раце, а она што во него по неколку дена израснало е прилично одвратно.
Сушилата за раце се популарни во јавните тоалети, но дали се хигиенски како што се мисли, многу е дискутабилно.
Една жена по име Никол Вард од Калифорнија тврди дека по нејзиниот експеримент, никогаш повеќе не треба повторно да ги ставаме рацете во такво сушило и затоа залудно сме ги миеле. Нејзината објава на Фејсбук е поделена на повеќе од половина милион пати и заработила скоро 150.000 допаѓања, а она што е на фотографијата прикажано, прилично е одвратно.
Никол, всушност, објавила фотографија од садот на Петри која се користи за набљудување на различни култури на бактерии и други микроорганизми, а кој пред неколку дена го ставила на три минути во сушило во јавен тоалет. Никол Вард тврди дека габите и бактериите израснале во садот, а фотографијата ја згрозила јавноста.
– Никогаш повеќе не ги сушете рацете во тој апарат. Ова се неколку видови на патогени габи и бактерии кои циркулираат околу вашите раце додека мислите дека тие се чисти. Нема на што – напишала Никол во нејзиното објава.
Иако не е познато дали има некаква научна основа, нејзиниот експеримент брзо се проширил на Интернет. Веродостојноста на оваа фотографија е лесно да се верува, бидејќи во 2016 година објавена е студија која покажала дека во сушилата за раце има 1300 пати повеќе бактерии отколку на хартиените крпи. Следниот пат, пред да одлучите да ги исушите рацете на тој начин, размислете добро дали ќе го направите тоа.
***Alright, Alright, Alright… now i think is a perfect time to tell you a few things. As y'all know how viral this…
Gepostet von Nichole Ward am Dienstag, 30. Januar 2018